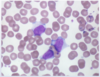
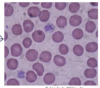
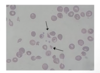

1st line of defense against bleeding
vasoconstriction; occurs in response to endothelial damage; key mediator: endothelins (blockers are used in pulmonary HTN)
Activated protein factors in the coagulation cascade
activated forms have an “a” added to their Roman numeral ex: 1a, Va, Xa
become *serine proteases
Thrombin
factor IIa; thrombin can make more thrombin via positive feedback ex: activates V, XI and VIII - a way to amplify the coagulation cascade
Factor VIII
produced in endothelial cells (not liver like other factors); circulates bound to vonWillebrand Factor; released in response to injury
VIII-vWF
Extrinsic Xase
TF bearing cells (injury), enzyme: Factor VIIa and Factor X as a substrate
all require phospholipids and calcium
Intrinsic Xase
platelets, enzyme: Factor IXa, co factors VIII and substrate Factor X
all require phospholipids and calcium
Calcium in the coagulation cascade
considered Factor IV and is REQUIRED for clot formation; activated platelets release Ca2+
NOTE: EDTA binds Ca2+ in blood samples and prevents clotting
Factor XII
aka Hageman factor
can activate factor XI
importance is for testing of coagulation system b/c it is activated by contact w negative charges (expose to silica)
basis for partial thromboplastin time (PTT)
Prekallikrein Deficiency
rare condition that results in MARKEDLY prolonged PTT due to an inability to activate XII normally (cannot activate bradykinin), but there are NO BLEEDING problems
usually comes known when pt has an abnormal PTT test
Coagulation Inhibitors
Antithrombin III
Proteins C and S
TF pathway inhibitor
Antithrombin III
a serpin (inhibitor of serine proteases); produced by the liver and activated by endothelium (make heparin sulfate molecules) - basis of the role of: heparin drug therapy
Deficiency = hyper coagulable state
Protein C and Protein S
glycoproteins synthesized in the liver as a zymogen (inactive) and activated into activated Protein C (APC) by thrombomodulin; works to primarily inactivate factors Va and VIIIa
Deficiency = hyper coagulable state
Tissue Factor pathway inhibitor
inactivates Xa via two mechanisms:
directly binds Xa
Binds TF/FVIIIa complex which then prevents X activation
plasma levels are increased when heparin is administered
Plasminogen activators
Tissue plasminogen activator (tPA) and urokinase; activated by streptokinase
used in therapy for acute MI and stroke
Primary Fibrinolysis
rare condition where plasmin is overactive; causes increased FDP with normal D-dimer
“hyperfibrinolysis” - no clot to cross linked fibrin means no products of breakdown = no D-dimers
plasmin can deplete clotting factors (similar to DIC) there will be increased PT/PTT w bleeding
seen in pts w prostate cancer: release of urokinase to cirrhosis: loss of alpha2 antiplasmin
Vitamin K
required for the synthesis of many clotting factors: II, VII, IX, X, C and S
Deficiency = bleeding
Warfarin is a vitamin K antagonist; pts on warfarin who take antibiotics that target gram (-) can develop supra therapeutic INR due to disruption of vitamin k producing intestinal flora
Erythrocyte Sedimentation Rate (ESR)
increased in inflammatory conditions by “acute phase reactant” ex: Fibrinogen, Ferritin and C-reactive protein (CRP)
Platelets
derived from megakaryocytes; do not contain a nucleus, regulated by thrombopoietin (TPO); aid in hemostasis and activated by injury
platelets actions
1st - adhesion: to sub-endothelium
2nd - aggregation: platelet-platelet binding
3rd - secretions: release of granule contents
Net result of sealing an opening in the vascular tree
von Willebrand Factor
a large glycoprotein synthesized by endothelial cells (in Weibel-Palade bodies) and megakaryocytes (alpha granules); released in vascular injury
3 important functions of VWF
1 - carrier protein for Factor VIII
2 - binds platelets to damaged endothelins
3 - binds activated platelets together (aggregation)
Platelet adhesion
vascular damage leads to exposed collagen, vWF binds the collagen and then vWF binds GP1b on platelets
Platelet aggregation
platelets have already underwent adhesion, now there is platelet activation mediated by GPIIb/IIIa receptor and now they can stick together via binding to fibrinogen or vWF linked to other platelets
Basis for IIb/IIIa receptor blocking drugs - blocks aggregation

Platelet secretion
platelets are activated by either binding to collagen or by activating substances
When one platelet is activated it can secrete substances to activate other platelets:
Alpha granules (most abundant) and Dense granules